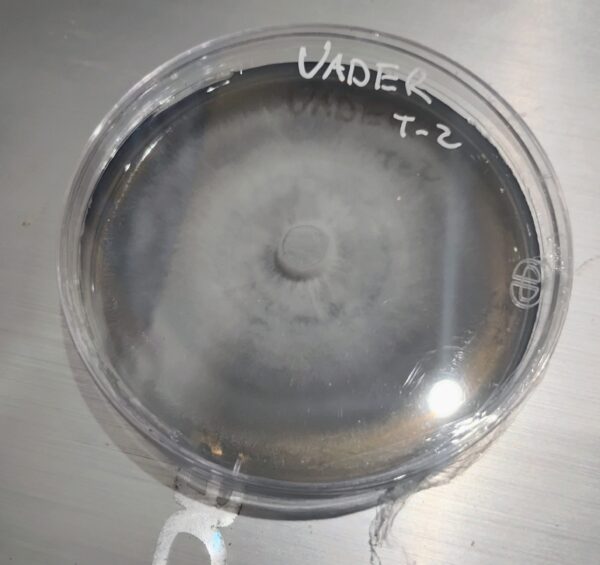

A cubensis hybrid of Melmak PE x Blue meanies (cube) . This genetic has produced 220 gram fruits multiple times. Large bodied fruits with Carmel color caps.
Vader
Related products
Be the first to review “Vader” Cancel reply
You must be logged in to post a review.

Reviews
There are no reviews yet.